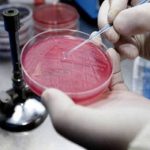
Bozza automatica 211

Allarme in Puglia dopo la diffusione dei dati Aress. Sempre più pazienti vanno a curarsi in Basilicata.
Scommettere sull’Albania, con una facoltà da avviare nella città di Valona, non è più un capriccio. È una necessità per supportare il processo di miglioramento del Sistema sanitario. Perché i dati sul comparto dimostrano che in Puglia c’è molto da fare. E soprattutto che le criticità non sono legate esclusivamente alla carenza di risorse economiche. C’è un problema di personale sempre più irreperibile (il fabbisogno annuale per la Puglia è di 600 specialisti, a fronte di soli 380 riconosciuti).
«Il più allarmante tra i dati – ha detto Giovanni Gorgoni, direttore Aress Puglia (Agenzia regionale per la salute e il sociale), presentando il Forum 2019 Mediterraneo in Sanità – è la disuguaglianza delle regioni del Sud rispetto a quelle del Nord, non tanto sul denaro quanto sul capitale umano, che è la vera debolezza del Sud. Le differenze in termini finanziari si possono aggiustare, se la politica lo vuole, nel giro di poco tempo. Le differenze in capitale umano, invece, non le sani in un anno, perché per fare un buon infermiere o un buon medico servono anni».
Ieri è arrivato a Bari il premier albanese Edi Rama per avere un incontro con il governatore Michele Emiliano (anche sull’argomento formazione). Le strutture stanno studiando la possibilità di avviare il corso di Medicina per formare i giovani laureati albanesi e italiani, a cui rilasciare il titolo abilitante in entrambi i Paesi. La collaborazione, in questa prima fase, nasce dalle università di Foggia (Medicina e Ospedali Riuniti) e di Bari (facoltà di Odontoiatria), mentre da Lecce dovrebbero arrivare le competenze in altri settori.
«Abbiamo firmato una convenzione – spiega Pierpaolo Limone, rettore dell’Università di Foggia – per avviare una collaborazione scientifica e didattica con un ateneo albanese. Forniremo docenze per qualificare i loro corsi di medicina e area sanitaria, e ospiteremo dottorandi albanesi a Foggia. Si tratta di un primo passo importante e intendiamo progressivamente incrementare la nostra presenza nei Balcani, magari di concerto con gli altri atenei pugliesi».
«È vero – spiega Loreto Gesualdo, presidente scuola di Medicina dell’Università di Bari –, ci hanno chiesto la disponibilità per un percorso di formazione in Odontoiatria». Nel corso del Forum Mediterraneo in Sanità è stato presentato il rapporto La salute diseguale. «Dal punto di vista tecnologico – ha proseguito Gorgoni –, la Regione Puglia è molto dinamica sulle soluzioni per l’invecchiamento attivo in salute. Ci è stato anche riconosciuto dall’Unione Europea. È notizia di poche ore fa che la Regione Puglia è uno dei reference site europei per le tecnologie e le politiche integrate a supporto dell’invecchiamento attivo. La Regione Puglia va sempre più verso la deospedalizzazione. Come livelli essenziali di assistenza, sono ormai tre anni che la Regione è in ascesa».
«La sanità pugliese mi è stata consegnata in condizioni molto gravi – ha sostenuto Emiliano –, ma sta migliorando sensibilmente. Certo, i pazienti continuano a segnalare difficoltà e noi dobbiamo risolvere i problemi. Stanno arrivando 5mila nuove assunzioni tra medici, infermieri e operatori sanitari. È il risultato del piano di riordino, che non ha chiuso nessun ospedale».
Intanto l’Aress ha effettuato una proiezione dei dati 2018 sulla mobilità passiva della sanità. E il bilancio mostra risultati sorprendenti. Il costo complessivo è di 200 milioni, ma il prezzo da pagare per i ricoveri fuori regione è a vantaggio soprattutto della Basilicata. Matera, infatti, è in seconda posizione, con un assegno annuale da incassare pari a 10 milioni. Nel rapporto con il Gemelli il salto negativo è di 13 milioni, mentre con il Bambino Gesù è di 9 milioni.
Redazione Nurse Times
Fonte: Corriere del Mezzogiorno

Lascia un commento